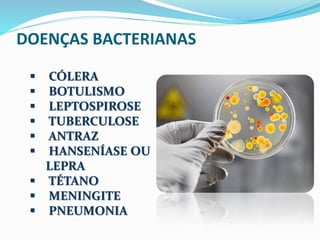
DOENÇAS BACTERIANAS 
 CÓLERA 
 BOTULISMO 
 LEPTOSPIROSE 
 TUBERCULOSE 
 ANTRAZ 
 HANSENÍASE OU 
LEPRA 
 TÉTANO 
 MENINGITE 
 PNEUMONIA

O Reino Monera compreende bactérias, cianobactérias e arqueobactérias, seres unicelulares e procariontes que desempenham papéis fundamentais na saúde e no meio ambiente. As bactérias se reproduzem predominantemente por bipartição e podem causar doenças como cólera e tuberculose, além de atuarem na produção de oxigênio e decomposição de matéria orgânica. As cianobactérias são autótrofas e possuem a capacidade de fixar nitrogênio atmosférico, contribuindo para a sucessão ecológica.